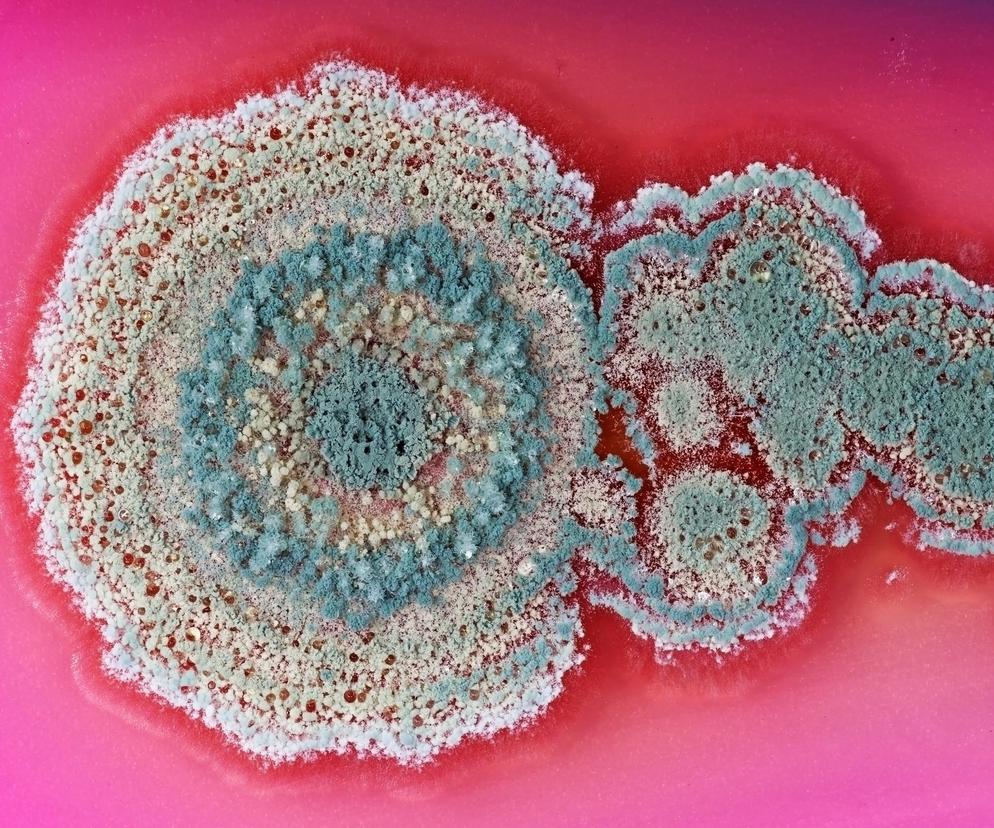
Lekooporny grzyb naprawdę może zagrozić ludzkości. WHO i CDC ostrzegają świat

Grzyb, który znalazł się na celowniku naukowców i ekspertów od zdrowia publicznego, to Candida auris, a dokładniej niedawno odkryty jego kolejny typ/szczep.
Nie pierwszy to raz, gdy Światowa Organizacja Zdrowia i CDC (amerykańska agencja w Departamencie Zdrowia i Opieki Społecznej) ostrzegają przed chorobotwórczymi grzybami, które stanowią szczególne zagrożenie dla pacjentów przewlekle chorych.
Niedawno jednak należący do drożdżaków Candida auris był co najwyżej numerem 4 wśród zagrożeń wskazywanych przez WHO. Teraz jednak zaskakująco szybko zmienia swoje oblicze na coraz bardziej agresywne.
Candida auris - co to za grzyb
Nowy typ groźnego drożdżaka odkryli naukowcy z trzech ośrodków badawczych w Singapurze.
Candida auris to grzyb wysoce zaraźliwy i trudny do wytępienia. Atakuje przede wszystkim pacjentów z poważnymi schorzeniami przewlekłymi, którzy wymagają stosowania inwazyjnego sprzętu medycznego: cewników, portów do podawania leków, rurek do oddychania i karmienia etc.
WHO i CDC uważają C. auris za potencjalne zagrożenie dla zdrowia publicznego, bo grzyb jest coraz trudniejszy do opanowania i trudno przewidzieć ostateczne konsekwencje jego inwazji.
Jak można zarazić się grzybicą?
Szósty typ Candida auris - co to dla nas oznacza?
- Konsekwencje tego odkrycia wykraczają daleko poza laboratorium. Teraz, gdy odkryliśmy szósty typ Candida auris, potrzeba ulepszenia możliwości kontroli lub opracowania nowych metod leczenia staje się pilną – przekonuje dr Karrie Ko, główna autorka badania i dyrektorka Genomiki Akademickiego Programu Klinicznego Patologii w ramach SingHealth i Duke-NUS Medical School.
Początkowo badacze sądzili, że pacjent przywiózł C. auris z podróży zagranicznej, ale ponieważ nie opuszczał Singapuru od dwóch lat, zdecydowano się na pogłębione badania. Analiza genomu grzyba dowiodła, że lekarze mają do czynienia z groźnym mutantem, a grzyb mutuje chętnie i często.
Badania kolejnych pacjentów w Singapurze pozwoliły rozpoznać kolejne przypadki zakażenia nowym szczepem.
Grozi nam pandemia?
Na razie nic nie wskazuje na to, by nowy C. auris był groźniejszy od 5 pozostałych typów. Wszystkie powodują ciężkie, rozległe, niejednokrotnie kończące się śmiercią zakażenia. Wciąż jednak dotyczą one przede wszystkim pacjentów hospitalizowanych z innego powodu, przewlekle chorych, z zaburzeniami układu odpornościowego.
Z drugiej strony C auris jest z nami bardzo krótko. Po raz pierwszy świat o nowym drożdżaku usłyszał zaledwie w 2009 roku. Od tamtej pory liczba diagnozowanych zakażeń rośnie lawinowo - od kilku przypadków rocznie do tysięcy.
W Polsce do tej pory stwierdzono zaledwie kilka przypadków zakażenia.
Uczeni, którzy wykryli kolejny typ grzyba nie mają wątpliwości, że konieczne jest nie tylko powszechne badanie pacjentów z grupy ryzyka w kierunku lekoopornych grzybic, ale przede wszystkim stworzenia narzędzi, które pozwolą dość szybko izolować nowe typy i mutacje patogenów.
To jeden z niezbędnych elementów ochrony świata przed kolejną pandemią. Może pozwolić zidentyfikować zagrożenie z odpowiednim wyprzedzeniem.
Źródła:
- CDC
- WHO
- https://www.thelancet.com/journals/lanmic/article/PIIS2666-5247(24)00101-0/fulltext